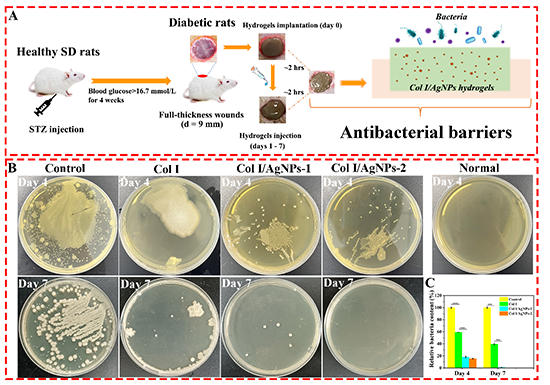

兰州大学肖建喜教授团队 CEJ:一步法合成原位银纳米颗粒可注射抗菌胶原蛋白水凝胶用于加速糖尿病伤口愈合
2024-01-08 来源:高分子科技
全球有5亿以上的糖尿病患者,其中三分之一患有慢性、容易感染的伤口,可能导致截肢等严重后果,是一个非常严峻的医疗挑战。治疗复杂的糖尿病伤口,需要良好活性的生物支架,以促进伤口修复,同时也需要优异抗菌功能的药物。胶原蛋白具有高生物相容性和生物活性,开发针对多重耐药菌的银纳米颗粒-胶原蛋白抗菌敷料为治疗糖尿病伤口提供了希望。然而,传统方法存在细胞毒性、步骤繁琐、不经济环保等问题。

图1. 一步法制备多功能胶原蛋白水凝胶,实现银离子交联胶原蛋白并同时原位合成银纳米颗粒。

图2. 胶原蛋白-银纳米颗粒复合水凝胶的合成与表征。
图3. 胶原蛋白-银纳米颗粒复合水凝胶在糖尿病全层伤口中形成抗菌屏障。

图4. 胶原蛋白-银纳米颗粒复合水凝胶治疗糖尿病伤口的性能评价。
该研究为开发可注射抗菌胶原蛋白水凝胶开辟了一条新的绿色高效的途径,以“One-step fabrication of an injectable antibacterial collagen hydrogel with in situ synthesized silver nanoparticles for accelerated diabetic wound healing”为题发表在《Chemical Engineering Journal》上(DOI: 10.1016/j.cej.2023.148288)。论文的第一作者是兰州大学博士研究生付彩虹,通讯作者为兰州大学肖建喜教授。该论文得到了国家自然科学基金和甘肃省重点研发计划的资助。
全文链接:https://doi.org/10.1016/j.cej.2023.148288
版权与免责声明:中国聚合物网原创文章。刊物或媒体如需转载,请联系邮箱:info@polymer.cn,并请注明出处。
(责任编辑:xu)
相关新闻
- 港中大(深圳)唐本忠院士团队 ACS Nano:可注射NIR-II水凝胶实现荧光成像引导的肥胖局部精准治疗 2026-05-24
- 华南理工大学杜金志教授、都小姣教授 ACS Nano:可注射“特洛伊木马”水凝胶 - 释放可穿透免疫刺激纳米胶束用于胶质母细胞瘤术后治疗 2026-04-20
- 复旦大学俞麟教授 AFM:可注射的热疗水凝胶通过调节炎症和细胞外基质代谢来抑制椎间盘退变 2026-04-05
- 给水凝胶做“瑜伽”拉伸5次,透明又抗压,成果登上 Science Advances 2026-06-16
- 厦门大学林友辉/南洋理工大学吴荣辉团队 Nat. Commun.:逐层剪切致密化实现块体水凝胶多尺度层级排列 2026-06-17
- 加州理工学院高伟课题组 Nat. Mater.:分子级整合弹性体-水凝胶双相材料 - 构建兼具组织粘附与多功能集成的新型生物电子平台 2026-06-12
- 东华大学陈志钢教授团队 AFM:钙离子输送的自泵式Janus膜用于糖尿病伤口愈合 2026-04-26
